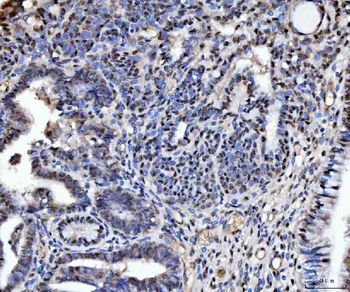
TIGD1 Rabbit Polyclonal Antibody
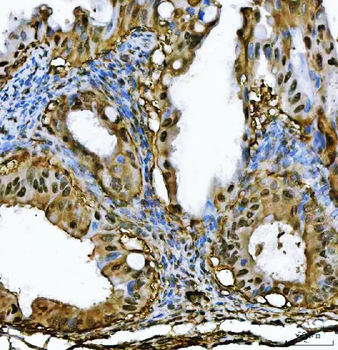
PSMB4 Rabbit Polyclonal Antibody

You have no items in your shopping cart.
All Products
- TIGD1 Rabbit Polyclonal Antibody [orb1291718]
ELISA, FC, ICC, IF, IHC, WB
Human, Mouse, Rat
Rabbit
Polyclonal
Unconjugated
100 μg - TBX18 Rabbit Polyclonal Antibody [orb1291728]
ELISA, FC, IF, IHC, WB
Human, Mouse, Rat
Rabbit
Polyclonal
Unconjugated
100 μg - TIP49A/RUVBL1 Rabbit Polyclonal Antibody [orb1173474]
ELISA, FC, ICC, IF, IHC, IP, WB
Human, Monkey, Mouse, Rat
Rabbit
Polyclonal
Unconjugated
100 μg - RPL36 Rabbit Polyclonal Antibody [orb1173476]
FC, IHC, WB
Human, Monkey, Mouse, Rat
Rabbit
Polyclonal
Unconjugated
100 μg - PSMB4 Rabbit Polyclonal Antibody [orb1173477]
ELISA, FC, IF, IHC, WB
Human, Mouse, Rat
Rabbit
Polyclonal
Unconjugated
100 μg - ATP5F1A Rabbit Polyclonal Antibody [orb1173502]
ELISA, FC, ICC, IF, IHC, WB
Human, Mouse, Rat
Rabbit
Polyclonal
Unconjugated
100 μg - XRCC4 Rabbit Polyclonal Antibody [orb1291632]
ELISA, FC, ICC, IF, IHC, WB
Human
Rabbit
Polyclonal
Unconjugated
100 μg - TOMM34 Rabbit Polyclonal Antibody [orb1402140]
ELISA, FC, IHC, WB
Human, Mouse, Rat
Rabbit
Polyclonal
Unconjugated
100 μg - SBP/SELENBP1 Rabbit Polyclonal Antibody [orb1402103]
ELISA, FC, IF, IHC, WB
Human, Mouse, Rat
Rabbit
Polyclonal
Unconjugated
100 μg - Vimentin Rabbit Polyclonal Antibody [orb1294389]
IF, IHC, IP, WB
Human, Mouse, Rat
Rabbit
Polyclonal
Unconjugated
100 μl, 25 μl